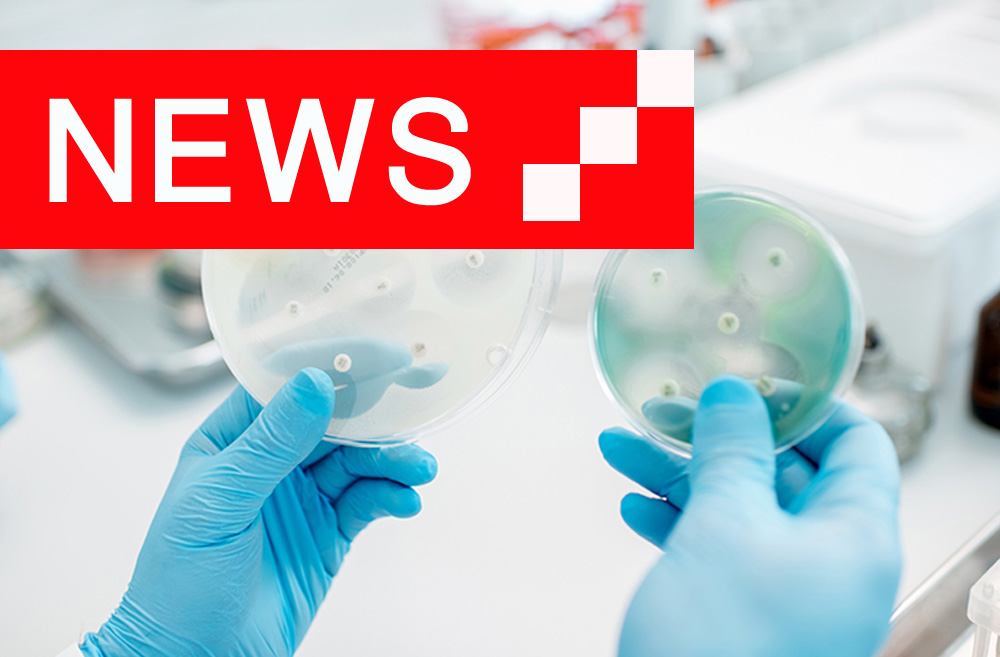

شرکت پادتن طب با مسئولیت محدود در سال 1366، در برهه ای از زمان که کشور نیاز مبرم به تولید کیت های تشخیصی آزمایشگاهی داشت تاسیس شد.
این شرکت با تولید 11 نوع دیسک آنتی بیوگرام شروع به فعالیت کرد و در زمان کوتاهی با اخذ مجوزهای لازم، تنوع محصولات خود را افزایش داد. در حال حاضر شرکت پادتن طب با تولید بیش از 100 مدل انواع دیسک های آنتی بیوگرام، تشخیصی و دامپزشکی و همچنین تولید سایر محصولات تشخیص آزمایشگاهی به عنوان اولین و بزرگترین تولید کننده دیسکهای آنتی بیوگرام در کشور و همچنین تنها تولید کننده کیت تشخیص Hb A2 شناخته می شود. …

اطلاع از انتقادات و پیشنهادات شما، ما را در بهبود هرچه بیشتر کیفیت محصولات و خدمات یاری می کند.
با ارائه انتقادات و پیشنهادات خود، ما را در بهبود گیفیت محصولات یاری بفرمایید.
طراحی وب سایت جدید شرکت پادتن طب در حال تکمیل می باشد. با توجه به این که وب سایت قبلی به دلیل ….

لورم ایپسوم متن ساختگی با تولید سادگی نامفهوم از صنعت چاپ و با استفاده از طراحان گرافیک است.